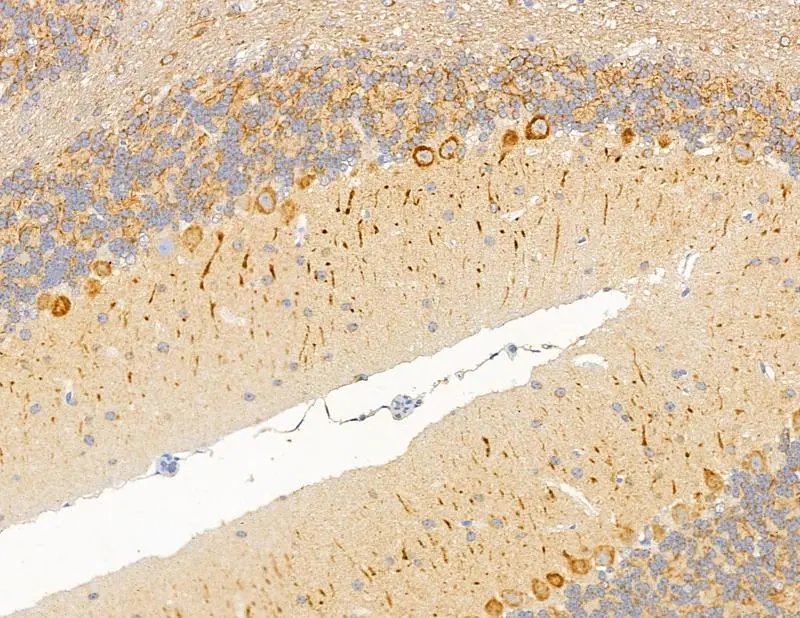

ICC/IF analysis of PFA fixed HeLa cells using GTX04514 MAP1A antibody. Red : Primary antibody Green : Beta tubulin Blue : DAPI
MAP1A antibody
GTX04514
ApplicationsImmunoFluorescence, Western Blot, ImmunoCytoChemistry, ImmunoHistoChemistry, ImmunoHistoChemistry Paraffin
Product group Antibodies
ReactivityHuman, Mouse, Rat
TargetMAP1A
Overview
- SupplierGeneTex
- Product NameMAP1A antibody
- Delivery Days Customer9
- Application Supplier NoteWB: 1:1000-1:3000. ICC/IF: 1:100-1:500. IHC-P: 1:50-1:200. *Optimal dilutions/concentrations should be determined by the researcher.Not tested in other applications.
- ApplicationsImmunoFluorescence, Western Blot, ImmunoCytoChemistry, ImmunoHistoChemistry, ImmunoHistoChemistry Paraffin
- CertificationResearch Use Only
- ClonalityPolyclonal
- Concentration1 mg/ml
- ConjugateUnconjugated
- Gene ID4130
- Target nameMAP1A
- Target descriptionmicrotubule associated protein 1A
- Target synonymsMAP1L, MTAP1A, microtubule-associated protein 1A, MAP-1A, proliferation-related protein p80
- HostRabbit
- IsotypeIgG
- Protein IDP78559
- Protein NameMicrotubule-associated protein 1A
- Scientific DescriptionThis gene encodes a protein that belongs to the microtubule-associated protein family. The proteins of this family are thought to be involved in microtubule assembly, which is an essential step in neurogenesis. The product of this gene is a precursor polypeptide that presumably undergoes proteolytic processing to generate the final MAP1A heavy chain and LC2 light chain. Expression of this gene is almost exclusively in the brain. Studies of the rat microtubule-associated protein 1A gene suggested a role in early events of spinal cord development. [provided by RefSeq, Jul 2008]
- ReactivityHuman, Mouse, Rat
- Storage Instruction-20°C or -80°C,2°C to 8°C
- UNSPSC12352203